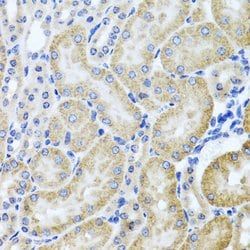
Img

RKHD1 Polyclonal Antibody, Invitrogen™
Manufacturer: Thermo Scientific
Select a Size
| Pack Size | SKU | Availability | Price |
|---|---|---|---|
| Each of 1 | PIPA595905-Each-of-1 | In Stock | ₹ 46,502.50 |
PIPA595905 - Each of 1
In Stock
Quantity
1
Base Price: ₹ 46,502.50
GST (18%): ₹ 8,370.45
Total Price: ₹ 54,872.95
Antigen
RKHD1
Classification
Polyclonal
Conjugate
Unconjugated
Gene
Mex3d
Gene Alias
BC059858, bcl-2 ARE RNA binding protein, KIAA2031, MEX3, mex3 homolog D (C. elegans), mex-3 RNA binding family member D, Mex3d, MEX-3D, OK/SW-cl.4, ring finger (C3HC4 type) and KH domain containing 1, ring finger and KH domain containing 1, RING finger and KH domain-containing protein 1, RING finger protein 193, RKHD1, RNA-binding protein MEX3D, RNF193, TINO
Host Species
Rabbit
Purification Method
Affinity Chromatography
Regulatory Status
RUO
Gene ID (Entrez)
237400
Content And Storage
-20° C, Avoid Freeze/Thaw Cycles
Form
Liquid
Applications
Western Blot
Concentration
0.54 mg/mL
Formulation
PBS with 50% glycerol and 0.01% thimerosal, pH 7.3
Gene Accession No.
Q3UE17
Gene Symbols
Mex3d
Immunogen
A synthetic peptide corresponding to a sequence within amino acids 500-600 of human MEX3D (NP_9760493)
Quantity
100 μL
Primary or Secondary
Primary
Target Species
Mouse
Product Type
Antibody
Isotype
IgG
Description
- Immunogen sequence: AGARRSSGAG TPRHSPTLPE PGGLRLELPL SRRGAPDPVG ALSWRPPQGP VSFPGGAAFS TATSLPSSPA AAACAPLDSG ASENSRKPPS ASSAPALARE C Rkhd1, also known as TINO or MEX3D is a member of a novel family of four homologous human MEX3 proteins each containing two heterogeneous nuclear ribonucleoprotein K homology (KH) domains and one carboxy-terminal RING finger module
- MEX3 proteins, including Rkhd1, are phosphoproteins that bind RNA through their KH domains and shuttle between the nucleus and the cytoplasm via the CRM1 export pathway
- These proteins are a novel family of evolutionarily conserved RNA-binding proteins, differentially recruited to P bodies and potentially involved in post-transcriptional regulatory mechanisms
- Rkhd1 binds to the AU-rich element in the 3’-untranslated region of Bcl-2 mRNA and is thought to be a negative regulator of Bcl-2 expression
- Rkhd3 and Rkhd4, but not Rkhd1, co-localize with both the hDcp1a decapping factor and Argonaute (Ago) proteins in processing bodies (P bodies), recently characterized as centers of mRNA turnover.